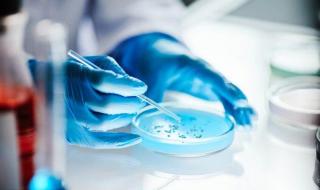

- رئيسي
- علوم وتكنولوجيا
جوجل
أعلنت شركة جوجل اليوم عن إطلاق وضع البحث بالذكاء الاصطناعي "AI Mode" على نطاق عالمي في أكثر من 180 دولة، شاملة الدول العربية.
ويتيح هذا الوضع للمستخدمين إجراء عمليات البحث عبر واجهة تفاعلية تشبه الدردشة، مع العلم أنه متاح حاليا فقط باللغة الإنجليزية ولا يدعم اللغة العربية.
وأفادت جوجل في بيان رسمي بأنها أضافت قدرات جديدة لوضع الذكاء الاصطناعي أطلقت عليها اسم "القدرات الوكيلية" (Agentic capabilities)، والتي تمكن المشتركين في خدمة "Google AI Ultra" المدفوعة من إجراء حجوزات المطاعم عبر إدخال تفاصيل مثل التاريخ والوقت والموقع وعدد الأشخاص ونوع المأكولات، حيث يقوم النظام بالبحث عبر منصات الحجز المختلفة وعرض قائمة بالمطاعم المتاحة مع روابط مباشرة لإتمام الحجز.
كما تسعى جوجل لجعل استجابات وضع الذكاء الاصطناعي أكثر تخصيصا عبر الاستناد إلى عمليات البحث السابقة وتفضيلات المستخدمين لتقديم اقتراحات أدق.
وإلى جانب ذلك، أضافت الشركة ميزة جديدة تتيح للمستخدمين مشاركة نتائج وضع الذكاء الاصطناعي عبر رابط يمكن نسخه ولصقه في الرسائل، مما يسمح للأصدقاء أو أفراد العائلة بمتابعة البحث من النقطة نفسها.
يذكر أن وضع البحث بالذكاء الاصطناعي /AI Mode/كان مقتصرا في البداية على الولايات المتحدة الأمريكية والمملكة المتحدة والهند.
للمزيد تابع
الخليج 24 على: فيسبوك | إكس | يوتيوب | إنستغرام | تيك توك